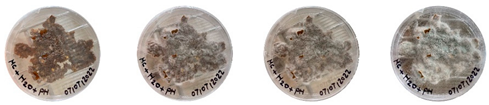
Biomimetics 08 00257 i018
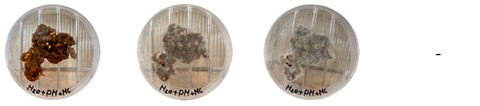
Biomimetics 08 00257 i019
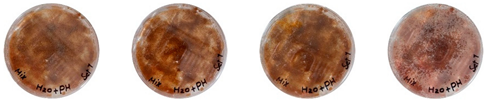
Biomimetics 08 00257 i021
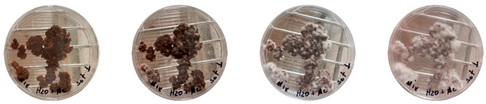
Biomimetics 08 00257 i022
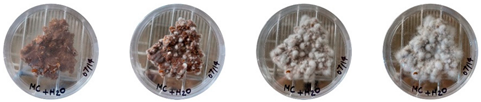
Biomimetics 08 00257 i034

Three-Dimensional Printing of Living Mycelium-Based Composites: Material Compositions, Workflows, and Ways to Mitigate Contamination
Abstract
1. Introduction
2. Background
2.1. Mycelium-Based Composites
2.2. Three-Dimensional Printing of Mycelium-Based Composites
2.3. Three-Dimensional Printing Workflow for Mycelium-Based Composites
2.3.1. Step 1: Mycelium Inoculation of Agricultural Feedstock
2.3.2. Step 2: Primary Colonization
2.3.3. Step 3: Mixing
2.3.4. Step 4: Three-Dimensional Printing
2.3.5. Step 5: Secondary Colonization
2.3.6. Step 6: Drying/Heating
2.4. Review of Previous Studies on 3D Printing of Mycelium-Based Composites
2.5. Contamination and Its Effect on Mycelial Growth
3. Materials and Methods
- (1)
- Development of extrudable mycelium-based mixtures.
- (2)
- Monitoring growth and tracking the source of contamination.
- (3)
- Three-dimensionally printing mycelium-based composites.
3.1. Development of Extrudable Mycelium-Based Mixtures with Waste Cardboard as Substrate
3.1.1. Collecting and Sorting Waste Cardboard
3.1.2. Substrate Preparation
3.1.3. Sterilization
3.1.4. Mycelium Inoculation and Primary Colonization
3.1.5. Preparation of Extrudable Mixtures
3.2. Monitoring Growth and Tracking the Source of Contamination
3.2.1. Isolating the Mixtures from Different Stages of Mixture Preparation to Track the Source of Contamination
3.2.2. Sterilization of Water and Psyllium Husk
3.3. Mitigating Contamination
3.3.1. Sterilization Check in PDA
3.3.2. Changes in the Working Protocols
- -
- A Laminar Airflow Workstation (biosafety hood) was used. All of the materials and tools used were kept under the biosafety hood during the mixing and sampling process. The workstation is an enclosed cabinet designed to prevent sensitive materials from being contaminated. The steel surfaces of the biosafety hood were sanitized by spraying 70% ethanol before working.
- -
- A Waring 700 G blender with a glass container was used for mixing the substrates. The glass container and all of the tools were carefully washed with Alconox detergent, left in the lab to dry, and sprayed with 70% ethanol solution before use.
- -
- A lab alcohol burner was used to produce an open flame for the flame sterilization of a stainless-steel scoop spatula.
- -
- An empty centrifuge tube was used to measure 2 g of sterile psyllium husk for each of the 1D, 1E, and 1F Petri dishes.
- -
- The colonizing-mycelium bag was cut using an aluminum-body cutting knife. The cutting knife was flame-sterilized before use. The colonizing mycelium was taken out of the bag using a sterilized stainless-steel spatula and was directly poured into the sterile glass blender to avoid contact with the hand or any external contamination source.
- -
- The glass bottle containing sterilized water was opened under the biosafety hood, and sterilized water was added to the blender.
- -
- The blender and all of the tools were washed and sterilized between experiment sets (D, E, and F).
- -
- All of the Petri dishes were sealed with parafilm before being moved outside the biosafety hood.
- -
- All of the nine Petri dishes were stored in a box and moved to a climate-controlled room at the Mushroom Research Center. They were regularly observed, and the changes were documented by taking photos on the 1st, 3rd, 5th, and 7th days of growth.
3.4. Three-Dimensional Printing of Mycelium-Based Composites with Waste Cardboard
3.4.1. Three-Dimensional Printing System and Hardware
3.4.2. Computational Workflow
3.4.3. Development of a Sterile, Isolated 3D Printing System
3.4.4. Drying and Heating 3D-Printed Samples
4. Results
4.1. Extrudability and Growth of the Mixtures
4.2. Tracking and Mitigating the Source of Contamination
4.2.1. Contamination Source in Mixtures from Different Stages of Mixture Preparation
- -
- A total of 100% of the Petri dishes with psyllium husk were contaminated.
- -
- Very early signs of contamination were visible starting on the 5th day.
- -
- The source of contamination was psyllium husk, the tools used for the 3D printing, or the working environment, and not the colonizing mycelium.
4.2.2. Effectiveness of Sterilization
4.3. Mitigating Contamination
4.3.1. Three-Dimensional Printing of Mycelium-Based Mixtures Cultivated with Waste Cardboard
4.3.2. The Sterile, Isolated 3D Printing System
5. Discussion
5.1. Limitations of the Study
5.2. Contributions
- -
- A comparative review of the existing 3D printing efforts for mycelium-based composites to date.
- -
- Recipes for extrudable mycelium mixtures, with waste cardboard as the primary substrate material.
- -
- A method to track the source of possible contamination using isolation in Petri dishes.
- -
- Ways to mitigate contamination using proper sterilization techniques and workflows.
5.3. Future Work
6. Conclusions
- -
- Waste cardboard is a feasible substrate for cultivating mycelia.
- -
- It is possible to develop extrudable mixtures that can be used for 3D-printing mycelium-based components with waste cardboard as a substrate.
- -
- One of the main challenges to 3D-printing mycelium-based composites is contamination.
- -
- Isolating mixtures from different stages of mixture preparation helps track and mitigate the source of contamination.
- -
- The ability to fabricate intricate and complex geometries while reducing formwork waste.
- -
- Contributing to waste reduction and sustainable fabrication practices by using waste cardboard as a primary substrate.
Author Contributions
Funding
Institutional Review Board Statement
Data Availability Statement
Conflicts of Interest
References
- Girometta, C.; Picco, A.M.; Baiguera, R.M.; Dondi, D.; Babbini, S.; Cartabia, M.; Pellegrini, M.; Savino, E. Physico-Mechanical and Thermodynamic Properties of Mycelium-Based Biocomposites: A Review. Sustainability 2019, 11, 281. [Google Scholar] [CrossRef]
- United Nations Environment Programme. 2020 Global Status Report for Buildings and Construction: Towards a Zero-Emission, Efficient and Resilient Buildings and Construction Sector. 2022. Available online: https://globalabc.org/sites/default/files/inline-files/2020%20Buildings%20GSR_FULL%20REPORT.pdf (accessed on 14 March 2022).
- Almpani-Lekka, D.; Pfeiffer, S.; Schmidts, C.; Seo, S. A review on architecture with fungal biomaterials: The desired and the feasible. Fungal Biol. Biotechnol. 2021, 8, 17. [Google Scholar] [CrossRef] [PubMed]
- Modanloo, B.; Ghazvinian, A.; Matini, M.; Andaroodi, E. Tilted Arch; Implementation of Additive Manufacturing and Bio-Welding of Mycelium-Based Composites. Biomimetics 2021, 6, 68. [Google Scholar] [CrossRef] [PubMed]
- Appels, F.; Camere, S.; Montalti, M.; Karana, E.; Jansen, K.M.B.; Dijksterhuis, J.; Krijgsheld, P.; Wosten, H. Fabrication factors influencing mechanical, moisture- and water-related properties of mycelium-based composites. Mater. Des. 2018, 161, 64–71. [Google Scholar] [CrossRef]
- Gantenbein, S.; Colucci, E.; Käch, J.; Trachsel, E.; Coulter, F.; Rühs, P.A.; Masania, K.; Studart, A. Three-dimensional Printing of Mycelium Hydrogels into Living Complex Materials. Nat. Mater. 2023, 22, 128–134. [Google Scholar] [CrossRef]
- Bhardwaj, A.; Vasselli, J.; Lucht, M.; Pei, Z.; Shaw, B.; Grasley, Z.; Wei, X.; Zou, N. 3D Printing of Biomass-Fungi Composite Material: A Preliminary Study. Manuf. Lett. 2020, 24, 96–99. [Google Scholar] [CrossRef]
- Yang, L.; Park, D.; Qin, Z. Material Function of Mycelium-Based Bio-Composite: A Review. Front. Mater. 2021, 8, 737377. [Google Scholar] [CrossRef]
- Ngo, T.D.; Kashani, A.; Imbalzano, G.; Nguyen, K.T.Q.; Hui, D. Additive manufacturing (3D printing): A review of materials, methods, applications and challenges. Compos. Part B Eng. 2018, 143, 172–196. [Google Scholar] [CrossRef]
- Block, P.; Mele, T.; Liew, A.; DeJong, M.; Escobedo, D.; Ochsendorf, J. Structural design, fabrication and construction of the Armadillo vault. Struct. Eng. 2018, 96, 10–20. [Google Scholar]
- Soh, E.; Chew, Z.Y.; Saeidi, N.; Javadian, A.; Hebel, D.; Ferrand, H.L. Development of an extrudable paste to build mycelium-bound composites. Mater. Des. 2020, 195, 109058. [Google Scholar] [CrossRef]
- Islam, M.R.; Tudryn, G.; Bucinell, R.; Schadler, L.; Picu, R.C. Morphology and mechanics of fungal mycelium. Sci. Rep. 2017, 7, 13070. [Google Scholar] [CrossRef]
- Jones, M.P.; Huynh, T.; Dekiwadia, C.; Daver, F.; John, S. Mycelium Composites: A Review of Engineering Characteristics and Growth Kinetics. J. Bionanosci. 2017, 11, 241–257. [Google Scholar] [CrossRef]
- Haneef, M.; Ceseracciu, L.; Canale, C.; Bayer, I.S.; Heredia-Guerrero, J.A.; Athanassiou, A. Advanced Materials from Fungal Mycelium: Fabrication and Tuning of Physical Properties. Sci. Rep. 2017, 7, 41292. [Google Scholar] [CrossRef]
- Jambaro, A.; Neri, K.; Alvarez, L. Utilization of Selected Urban Wastes as Substrate Solutions in the Growth and Yield Performance of Pleurotus sajor-caju Fr. (Singer) (Gray Oyster mushroom). PUP J. Sci. Technol. 2014, 7, 28–44. [Google Scholar]
- Ghazvinian, A.; Farrokhsiar, P.; Rocha Vieira, F.; Pecchia, J.; Gursoy, B. Mycelium-Based Bio-Composites for Architecture: Assessing the Effects of Cultivation Factors on Compressive Strength. Mater. Res. Innov. 2019, 2, 505–514. [Google Scholar] [CrossRef]
- Attias, N.; Danai, O.; Abitbol, T.; Tarazi, E.; Ezov, N.; Pereman, I.; Grobman, Y.J. Mycelium bio-composites in industrial design and architecture: Comparative review and experimental analysis. J. Clean. Prod. 2020, 246, 119037. [Google Scholar] [CrossRef]
- Grünewald, J.; Parlevliet, P.; Altstädt, V. Manufacturing of thermoplastic composite sandwich structures: A review of literature. J. Thermoplast. Compos. Mater. 2017, 30, 437–464. [Google Scholar] [CrossRef]
- Yang, Z.; Zhang, F.; Still, B.; White, M.; Amstislavski, P. Physical and Mechanical Properties of Fungal Mycelium-Based Biofoam. J. Mater. Civ. Eng. 2017, 29, 04017030. [Google Scholar] [CrossRef]
- Bhardwaj, A.; Rahman, A.M.; Wei, X.; Pei, Z.J.; Truong, D.; Lucht, M.; Zou, N. 3D Printing of Biomass–Fungi Composite Material: Effects of Mixture Composition on Print Quality. J. Manuf. Mater. Process. 2021, 5, 112. [Google Scholar] [CrossRef]
- Ghazvinian, A. A Sustainable Alternative to Architectural Materials: Mycelium-based Bio-Composites. In Proceedings of the Divergence in Architectural Research, Atlanta, GA, USA, 15 February 2021; Georgia Institute of Technology: Atlanta, GA, USA, 2021; pp. 159–167. [Google Scholar]
- Grimm, A.; Eilertsen, L.; Chen, F.; Huang, R.; Atterhem, L.; Xiong, S. Cultivation of Pleurotus ostreatus Mushroom on Substrates Made of Cellulose Fibre Rejects: Product Quality and Spent Substrate Fuel Properties. Waste Biomass Valorization 2021, 12, 4331–4340. [Google Scholar] [CrossRef]
- Abhijith, R.; Ashok, A.; Rejeesh, C.R. Sustainable packaging applications from mycelium to substitute polystyrene: A review. Mater. Today Proc. 2018, 5, 2139–2145. [Google Scholar] [CrossRef]
- Jones, M.P.; Huynh, T.; John, S. Inherent species characteristic influence and growth performance assessment for mycelium composite applications. Adv. Mater. Lett. 2018, 9, 71–80. [Google Scholar] [CrossRef]
- Long, W.-J.; Tao, J.-L.; Lin, C.; Gu, Y.; Mei, L.; Duan, H.-B.; Xing, F. Rheology and buildability of sustainable cement-based composites containing micro-crystalline cellulose for 3D-printing. J. Clean. Prod. 2019, 239, 118054. [Google Scholar] [CrossRef]
- Elsacker, E. Mycelium Matters—An Interdisciplinary Exploration of the Fabrication and Properties of Mycelium-Based Materials. Ph.D. Thesis, Vrije Universiteit Brussel, Brussel, Belgium, 2021. [Google Scholar] [CrossRef]
- Ghazvinian, A.; Khalilbeigi Khameneh, A.; Mottaghi, E.; Gursoy, B. A Computational Framework for the Design and Fabrication of Spatial Structures with Mycelium-based Composites. In Proceedings of the IASS Annual Symposia, Guildford, UK, 23–27 August 2021. [Google Scholar]
- Elsacker, E.; Peeters, E.; De Laet, L. Large-scale robotic extrusion-based additive manufacturing with living mycelium materials. Sustain. Futur. 2022, 4, 100085. [Google Scholar] [CrossRef]
- Goidea, A.; Andreen, D.; Floudas, D. Pulp Faction: 3D Printed Material Assemblies through Microbial Biotransformation; UCL Press: London, UK, 2020. [Google Scholar]
- Hahn, J. Blast Studio 3D Prints Column from Mycelium to Make “Architecture That Could Feed People”. 2022. Available online: https://www.dezeen.com/2022/01/18/blast-studio-tree-column-mycelium-design/ (accessed on 6 August 2022).
- Jauk, J.; Vašatko, H.; Gosch, L.; Christian, I.; Klaus, A.; Stavric, M. Digital Fabrication of Growth Combining digital manufacturing of clay with natural growth of mycelium. In Proceedings of the 26th International Conference of the Association for Computer-Aided, Hong Kong, China, 29 March–1 April 2021. [Google Scholar]
- Lim, A.C.S.; Thomsen, M.R. Multi-material Fabrication for Biodegradable Structures: Enabling the printing of porous mycelium composite structures. In Proceedings of the eCAADe 2021: Towards a New, Configurable Architecture, Novi Sad, Serbia, 8 September–10 September 2021; pp. 85–94. Available online: http://www.ecaade2021.ftn.uns.ac.rs/ (accessed on 3 May 2023).
- Grow It YourselfTM Material. Grow.bio. Available online: https://grow.bio/products/grow-it-yourself-material (accessed on 3 May 2023).
- Innocenti, G.; Montanari, M.; Righini, H.; Roberti, R. Trichoderma species associated with green mould disease of Pleurotus ostreatus and their sensitivity to prochloraz. Plant Pathol. 2019, 68, 392–398. [Google Scholar] [CrossRef]
- Park, M.S.; Bae, K.S.; Yu, S.H. Two New Species of Trichoderma Associated with Green Mold of Oyster Mushroom Cultivation in Korea. Mycobiology 2006, 34, 111–113. [Google Scholar] [CrossRef]
- Danesh, Y.R.; Goltapeh, E.M.; Rohani, H. Identification of Trichoderma species causing green mould in button mushroom farms, distribution and their relative abundance. Sci. Cultiv. Edible Fungi 2000, 2, 653–659. [Google Scholar]
- Cao, Z.-J.; Qin, W.-T.; Zhao, J.; Liu, Y.; Wang, S.-X.; Zheng, S.-Y. Three New Trichoderma Species in Harzianum Clade Associated with the Contaminated Substrates of Edible Fungi. J. Fungi 2022, 8, 1154. [Google Scholar] [CrossRef]
- Pakeerthan, K. Eco-Friendly Management Common Lab Contaminant Trichoderma spp. in Oyster mushroom Production Using Agrobased Industry’s by-Products. In Proceedings of the International Conference on Climate Change, Virtual, 18–19 February 2021; Available online: https://tiikmpublishing.com/proceedings/index.php/iccc/article/view/733 (accessed on 23 February 2023).
- National Overview: Facts and Figures on Materials, Wastes and Recycling. 2021. Available online: https://www.epa.gov/facts-and-figures-about-materials-waste-and-recycling/national-overview-facts-and-figures-materials (accessed on 8 October 2021).
- Owaid, M.; Abed, A.; Nassar, B. Recycling cardboard wastes to produce blue oyster mushroom Pleurotus ostreatus in Iraq. Emir. J. Food Agric. 2015, 27, 537–541. [Google Scholar] [CrossRef]
- Bellettini, M.B.; Fiorda, F.A.; Maieves, H.A.; Teixeira, G.L.; Ávila, S.; Hornung, P.S.; Júnior, A.M.; Ribani, R.H. Factors affecting mushroom Pleurotus spp. Saudi J. Biol. Sci. 2019, 26, 633–646. [Google Scholar] [CrossRef]
- Nguyen, M.; Ranamukhaarachchi, S. Study on the mycelium growth and primordial formation of king oyster mushroom (Pleurotus eryngii) on cardboard and spent coffee ground. Res. Crops 2019, 20, 835–842. [Google Scholar] [CrossRef]
- 3D Potter. Frequently Asked Questions (FAQ) about Clay 3D Ceramic Printers and 3D Potterbot—3D Potter Real Clay 3D Ceramic Printers. Available online: https://3dpotter.com/faq-v789 (accessed on 23 February 2023).





| Pulp Faction [29] | Tilted Arch [4] | Mycelium Matters [28] | Mycelium-Bound Composite [11] | MyCera [31] | Multi-Material Fabrication [32] | 3D Printing of Biomass-Fungi Composite Material [7] | 3D Printing of Biomass-Fungi Composite Material II [20] | |
|---|---|---|---|---|---|---|---|---|
![]() | ![]() | ![]() | ![]() | ![]() | ![]() | ![]() | ![]() | |
| Sequence of steps | 1-2-3-4-5-6 | 1-2-3-4-5-6 | 1-2-3-4-5-6 | 1-2-3-4-5-6 | 3-4-1-2-5-6 | 1-2-3-4-5-6 | 1-2-3-4-5-6 | 1-2-3-4-5-6 |
| Step 1: Mycelium Inoculation of Agricultural Feedstock | ||||||||
| Mixture | Fine woodchips + paper pulp + kaolin clay | Shredded paper + wheat bran | Beechwood + paper cellulose | Bamboo fibers (500 μm) | Sawdust (<2 mm) + bleached and unbleached cellulose | Paper pulp + secondary material: sand (0.02–0.05 mm) and gravel (4–8 mm) | Ecovative GIY mixture [33] | Ecovative GIY mixture ([33] |
| Ratio | N/A | 65–70 wt% water + 7% wheat bran (dry weight) | 64 wt% water | 175 g of bamboo fibers + 175 mL of water + 50 g of spawn + sawdust | N/A | N/A | 400 g of Ecovative mixture + 700 mL water + 32 g flour | 400 g of Ecovative mixture + 700 mL water + 32 g flour |
| Fungal strains | Byssomerulius corium + Gloeophyllum | Pleurotus ostreatus (10% of dry weight content) | Trametes versicolor + Ganoderma resinaceum | Ganoderma lucidum | Pleurotus ostreatus | Ganoderma Lucidum | N/A | N/A |
| Step 2: Primary Colonization | ||||||||
| First incubation period | 7 days | 14 days | 14 days | 1 to 4 weeks | N/A | N/A | 3–5 days | 3–5 days |
| Step 3: Mixing | ||||||||
| Gelling agent | Kaolin Clay | Guar gum | Xanthan gum (3 wt%) | Chitosan | Clay | Xanthan gum | Psyllium husk powder | Psyllium husk powder |
| Ratio | N/A | 3:50 Guar gum:water | 10–80 wt% fiber-water /5–85 wt% fiber-water | 60:40 and 70:30 fiber ratios + 3 wt% chitosan solution at pH~6 | 7:1 clay: sawdust + 35 wt% water | 11% spawn, 56% paper pulp, 1% xanthan gum, and 32% water (by weight) | 100 g of primary material + 400 g of water + psyllium husk (20 g) | 100 g of primary material + 400 g of water + psyllium husk (0, 10 g, 20 g, or 30 g) |
| Method | N/A | N/A | 20 min at 400 rpm | Pounded with pestle and mortar | Mixing machine | N/A | Commercial mixer for 30 s | Commercial mixer for 15 s |
| Step 4: 3D Printing | ||||||||
| Printer | Vormvrij Lutum v4 | Custom extruder | KUKA KR 15/2 6-axis industrial robot | Manually with serological syringes | Delta WASP 40100 | N/A | Delta WASP 2040 | Delta WASP 2040 |
| Nozzle diameter | 3.5 mm | 9 mm | N/A | 6 mm | 4 mm | N/A | 4 mm | N/A |
| Layer height | 1.5 mm | N/A | 3 mm | N/A | N/A | N/A | N/A | N/A |
| Print speed | N/A | N/A | N/A | N/A | N/A | N/A | 15 mm/s + air pressure of 3.5 bar | 30 mm/s |
| Step 5: Secondary Colonization | ||||||||
| Second incubation period | N/A | 5 weeks + 7 days of biowelding | 7 days at 26 °C | 20 days | 2 weeks at 24 °C | 14 days | 3–5 days | N/A |
| Step 6: Drying/Heating | ||||||||
| Drying period | N/A | N/A | N/A | Overnight at 40 °C | 6 h at 600 °C + 2.5 h at 960 °C | N/A | 4 h at 95 °C | N/A |
| Shrinkage | 40% | N/A | N/A | 3–6% | N/A | N/A | N/A | N/A |
| Colonized Mycelium: Distilled Water: Psyllium Husk M:W:PH (by Weight) | |
|---|---|
| Mixture A | 5:20:2 |
| Mixture B | 10:20:1 |
| Mixture C | 5:10:1 |
| Mixture D | 10:10:1 |
| Mixture E | 10:5:1 |
| Petri Dishes #1A, #1B, and #1C | Petri Dishes #2A, #2B, and #2C | Petri Dishes #3A, #3B, and #3C | Petri Dishes #4A, #4B, and #4C |
|---|---|---|---|
Psyllium husk + water PH (2 g) + W (20 g) | Colonizing mycelium + water M (5 g) + W (20 g) | Colonizing mycelium + water + psyllium husk M (5 g) + W (20 g) + PH (2 g) | Extruded Colonizing mycelium + water + psyllium husk M (5 g) + W (20 g) + PH (2 g) |
| Petri Dishes #1D, #1E, and #1F | Petri Dishes #2D, #2E, and #2F | Petri Dishes #3D, #3E, and #3F |
|---|---|---|
| Psyllium husk + water PH (2 g) + W (20 g) | Colonizing mycelium + water M (5 g) + W (20 g) | Colonizing mycelium + water + psyllium husk M (5 g) + W (20 g) + PH (2 g) |
| Extrusion Method | Mixture | Extrudability | Consistency | Mycelial Growth |
|---|---|---|---|---|
| Medical syringe | Mixture A | Extruded | Consistent | Fully grown |
| Mixture B | Extruded | Consistent | Slight growth | |
| Mixture C | Extruded | Consistent | Slight growth | |
| Mixture D | Extruded | Inconsistent | No growth | |
| Mixture E | Not extruded | - | - | |
| 3D PotterBot (5 mm nozzle) | Mixture A | Extruded | Consistent | Fully grown |
| Mixture B | Extruded | Inconsistent | Fully grown | |
| Mixture C | Extruded | Inconsistent | Fully grown | |
| Mixture D | Extruded | Inconsistent | Slight growth | |
| Mixture E | Not extruded | - | - |
| Experiment | 1st Day | 3rd Day | 5th Day | 7th Day | |
|---|---|---|---|---|---|
| A | Petri dish #1A Psyllium husk + water W (20 g) + PH (2 g) | ![]() | |||
| Petri dish #2A Colonizing mycelium + water M (5 g) + W (20 g) | ![]() | ||||
| Petri dish #3A Colonizing mycelium + water + psyllium husk M (5 g) + W (20 g) + PH (2 g) | ![]() | ||||
| Petri dish #4A Extruded Colonizing mycelium + water + psyllium husk M (5 g) + W (20 g) + PH (2 g) | ![]() | ||||
| B | Petri dish #1B Psyllium husk + water W (20 g) + PH (2 g) | ![]() | |||
| Petri dish #2B Colonizing mycelium + water M (5 g) + W (20 g) | ![]() | ||||
| Petri dish #3B Colonizing mycelium + water + psyllium husk M (5 g) + W (20 g) + PH (2 g) | ![]() | ||||
| Petri dish #4B Extruded Colonizing mycelium + water + psyllium husk M (5 g) + W (20 g) + PH (2 g) | ![]() | ||||
| C | Petri dish #1C Psyllium husk + water W (20 g) + PH (2 g) | ![]() | |||
| Petri dish #3C Colonizing mycelium + water + psyllium husk M (5 g) + W (20 g) + PH (2 g) | ![]() | ||||
| Petri dish #4C Extruded Colonizing mycelium + water + psyllium husk M (5 g) + W (20 g) + PH (2 g) | ![]() | ||||
| Psyllium Husk + Water W (20 g) + PH (2 g) | Psyllium Husk on PDA PH (2 g) | Water on PDA W (20 g) | Water on PDA (after Working) W (20 g) |
|---|---|---|---|
![]() | |||
| Experiment | 1st Day | 3rd Day | 5th Day | 7th Day | |
|---|---|---|---|---|---|
| D | Petri dish #1D Psyllium husk + water W (20 g) + PH (2 g) | ![]() | |||
| Petri dish #2D Colonizing mycelium + water M (5 g) + W (20 g) | ![]() | ||||
| Petri dish #3D Colonizing mycelium + water + psyllium husk M (5 g) + W (20 g) + PH (2 g) | ![]() | ||||
| E | Petri dish #1E Psyllium husk + water W (20 g) + PH (2 g) | ![]() | |||
| Petri dish #2E Colonizing mycelium + water M (5 g) + W (20 g) | ![]() | ||||
| Petri dish #3D Colonizing mycelium + water + psyllium husk M (5 g) + W (20 g) + PH (2 g) | ![]() | ||||
| F | Petri dish #1E Psyllium husk + water W (20 g) + PH (2 g) | ![]() | |||
| Petri dish #2E Colonizing mycelium + water M (5 g) + W (20 g) | ![]() | ||||
| Petri dish #3F Colonizing mycelium + water + psyllium husk M (5 g) + W (20 g) + PH (2 g) | ![]() | ||||
| Experiment | 1st Day | 3rd Day | 5th Day | 7th Day | |
|---|---|---|---|---|---|
| 3D-Printed prototypes | 3D-Printed prototype #1 | ![]() | |||
| 3D-Printed prototype #2 | ![]() | ||||
| 3D-Printed prototype #3 | ![]() | ||||
| G | Petri dish #1G Psyllium husk + water W (20 g) + PH (2 g) | ![]() | |||
| Petri dish #2G Colonizing mycelium + water M (5 g) + W (20 g) | ![]() | ||||
| Petri dish #3G Colonizing mycelium + water + psyllium husk M (5 g) + W (20 g) + PH (2 g) | ![]() | ||||
| Petri dish #4C Extruded Colonizing mycelium + water + psyllium husk M (5 g) + W (20 g) + PH (2 g) | ![]() | ||||
Disclaimer/Publisher’s Note: The statements, opinions and data contained in all publications are solely those of the individual author(s) and contributor(s) and not of MDPI and/or the editor(s). MDPI and/or the editor(s) disclaim responsibility for any injury to people or property resulting from any ideas, methods, instructions or products referred to in the content. |
© 2023 by the authors. Licensee MDPI, Basel, Switzerland. This article is an open access article distributed under the terms and conditions of the Creative Commons Attribution (CC BY) license (https://creativecommons.org/licenses/by/4.0/).
Share and Cite
Mohseni, A.; Vieira, F.R.; Pecchia, J.A.; Gürsoy, B. Three-Dimensional Printing of Living Mycelium-Based Composites: Material Compositions, Workflows, and Ways to Mitigate Contamination. Biomimetics 2023, 8, 257. https://doi.org/10.3390/biomimetics8020257
Mohseni A, Vieira FR, Pecchia JA, Gürsoy B. Three-Dimensional Printing of Living Mycelium-Based Composites: Material Compositions, Workflows, and Ways to Mitigate Contamination. Biomimetics. 2023; 8(2):257. https://doi.org/10.3390/biomimetics8020257
Chicago/Turabian StyleMohseni, Alale, Fabricio Rocha Vieira, John A. Pecchia, and Benay Gürsoy. 2023. "Three-Dimensional Printing of Living Mycelium-Based Composites: Material Compositions, Workflows, and Ways to Mitigate Contamination" Biomimetics 8, no. 2: 257. https://doi.org/10.3390/biomimetics8020257
APA StyleMohseni, A., Vieira, F. R., Pecchia, J. A., & Gürsoy, B. (2023). Three-Dimensional Printing of Living Mycelium-Based Composites: Material Compositions, Workflows, and Ways to Mitigate Contamination. Biomimetics, 8(2), 257. https://doi.org/10.3390/biomimetics8020257